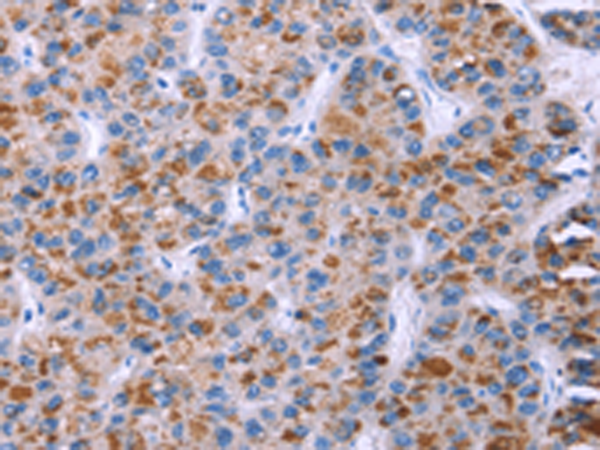

-
分类: 科研抗体货号: P11729别名: DYN2; CMT2M; DYNII; LCCS5; CMTDI1; CMTDIB; DI-CMTB应用: WB,IHC反应种属: Human, Mouse, Rat
-
分类: 科研抗体货号: P11740别名: EP; DBAL; ECYT5; MVCD2应用: WB,IHC反应种属: Human, Mouse, Rat
-
分类: 科研抗体货号: P11746别名: ESP1; SEPA应用: IHC反应种属: Human, Mouse
-
分类: 科研抗体货号: P11724别名: NSX; POLA; p180应用: WB反应种属: Human, Mouse, Rat
-
分类: 科研抗体货号: P11739别名: AF1; EFL5; RAGS; EPLG7; GLC1M; LERK7应用: IHC反应种属: Human, Mouse, Rat
-
分类: 科研抗体货号: P11745别名: ERR2; ERRb; ESRL2; NR3B2; DFNB35应用: IHC反应种属: Human
-
分类: 科研抗体货号: P11761别名: EPRAP应用: IHC反应种属: Human
-
分类: 科研抗体货号: P11738别名: p300; KAT3B; RSTS2应用: IHC反应种属: Human, Mouse
-
分类: 科研抗体货号: P11744别名: IRE1b; IRE1-BETA应用: IHC反应种属: Human
-
分类: 科研抗体货号: P11758别名: FAT; ME5; CDHF7; CDHR8; hFat1应用: IHC反应种属: Human

鄂公网安备42018502007531号
鄂公网安备42018502007531号

